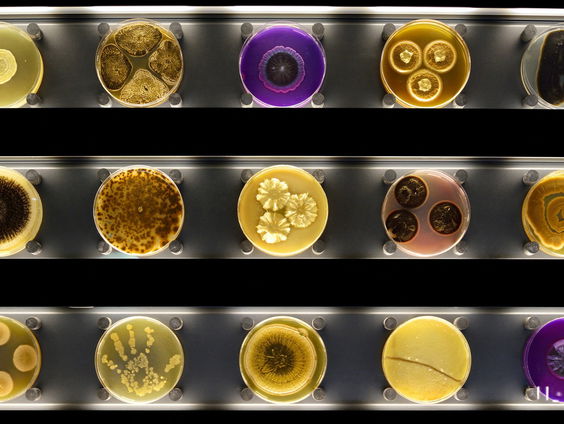
Wat is een microbe nou precies?

Uitzending gemist
Humberto
- Gids
- Humberto
Gepresenteerd door: Humberto Tan
Elke vrijdagmiddag luidt Humberto Tan het weekend in met een programma waarin hij op zoek gaat naar de diepere lagen bij het nieuws. “Als je als metafoor stelt dat nieuws vaak een weerbericht is, dan wil ik het over het klimaat hebben. Wat zijn de bepalende momenten in een ontwikkeling, wanneer kun je van een doorbraak spreken? Pas als je uitzoomt, zie je de grotere verbanden.” Naast interviews met mensen uit het nieuws vormen gesprekken met vaste gasten, muziek en een vooruitblik op het weekend wezenlijke onderdelen van het programma.
.jpg?height=424&width=564&aspect_ratio=141%3A106)